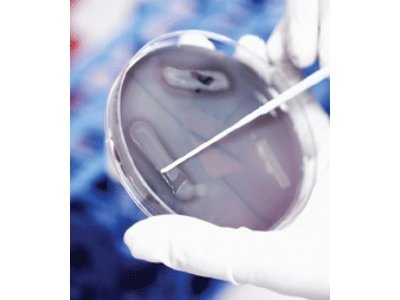
AXIMA-iD Plus Microorganism Analysis

Shimadzu
Visit Website121 products
Shimadzu Corporation is a Japanese manufacturer of precision instruments, Founded in 1875 and headquartered in Kyoto, Japan. The company specializes in analytical and measuring instruments including chromatographs, And industrial machinery. Its laboratory product portfolio spans spectroscopy

UV-1280 Monitored Single-Beam UV-Vis Spectrophotometer
Shimadzu
SKU: UV-1280

ALTRACE Energy Dispersive X-Ray Fluorescence Spectrometer
Shimadzu
SKU: ALTRACE

EDX-7200 Energy Dispersive X-ray Fluorescence Spectrometer
Shimadzu
SKU: EDX-7200

EDX-8100 Energy Dispersive X-ray Fluorescence Spectrometer
Shimadzu
SKU: EDX-8100

EDX-LE Energy Dispersive X-ray Fluorescence Spectrometer
Shimadzu
SKU: EDX-LE

SALD-2300 Laser Diffraction Particle Size Analyzer
Shimadzu
SKU: SALD-2300

iSpect DIA-10 Dynamic Image Particle Size and Shape Analyzer
Shimadzu
SKU: iSpect

2D HPLC for Bioanalysis (Co-Sense for BA)
Shimadzu
SKU: Co-Sense for BA

GCMS-QP2050 Single Quadrupole GC-MS
Shimadzu
SKU: GCMS-QP2050 Single Quadrupole GC-MS

MDGC/GCMS-2010 Multi Dimensional Gas Chromatograph Systems
Shimadzu
SKU: MDGC/GCMS-2010

Nexis SCD-2030 Sulfur Chemiluminescence Detection System
Shimadzu
SKU: SCD-2030

GCMS-QP2020 NX Gas Chromatograph Mass Spectrometer (GC/MS)
Shimadzu
SKU: GCMS-QP2020 NX

ICPMS-2030 Inductively Coupled Plasma Mass Spectrometer
Shimadzu
SKU: ICPMS-2030

ICPE-9800 Series Simultaneous ICP Emission Spectrometers
Shimadzu
SKU: ICPE-9800

LCMS-2020 Single Quadrupole Mass Spectrometer
Shimadzu
SKU: LCMS-2020

LCMS-8060RX Triple Quadrupole LC/MS/MS Mass Spectrometer
Shimadzu
SKU: LCMS-8060RX

LCMS-8065XE Triple Quadrupole LC/MS/MS Mass Spectrometer
Shimadzu
SKU: LCMS-8065XE

LCMS-TQ RX Series Triple Quadrupole LC-MS/MS
Shimadzu
SKU: LCMS RX Series

Nexera Mikros Microflow Liquid Chromatography Mass Spectrometer System
Shimadzu
SKU: Nexera Mikros

Nexera UCs UHPLC/SFC Switcing System
Shimadzu
SKU: Nexera UC Switching

Axima Assurance MALDI Time of Flight Mass Spectrometer
Shimadzu
SKU: AXIMA Assurance

Axima Confidence MALDI TOF Mass Spectrometer
Shimadzu
SKU: Axima Confidence

Axima Performance MALDI TOF TOF Mass Spectrometer
Shimadzu
SKU: Axima Performance

MALDI-8020 EasyCare Benchtop Linear MALDI-TOF Mass Spectrometer
Shimadzu
SKU: MALDI-8020

MALDI-8030 EasyCare Benchtop Linear Dual Polarity MALDI-TOF Mass Spectrometer
Shimadzu
SKU: MALDI-8030

OmegaTOF Benchtop High Mass MALDI-TOF Mass Spectrometer
Shimadzu
SKU: OmegaTOF

AP Series Analytical Balances
Shimadzu
SKU: AP135W / AP125WD / AP225WD / AP124W / AP224W / AP324W / AP124X / AP224X / AP324X / AP124Y / AP224Y / AP324Y

Nexera Gel Permeation Chromatography (GPC) System
Shimadzu
SKU: Nexera GPC

AGS-V Tabletop Precision Universal Testing Machines
Shimadzu
SKU: AGS-V Series

AGX-V2 Series Universal Electromechanical Test Frames
Shimadzu
SKU: AGX-V2

HMV-G Series Micro Vickers Hardness Testers
Shimadzu
SKU: HMV-G

EZ-X Series Tabletop Materials Testers
Shimadzu
SKU: EZ-SX / EZ-LX / EZ-LX HS

UH-X/FX Series Universal Testing Machines
Shimadzu
SKU: UH-200kNX / UH-200kNXh / UH-300kNX / UH-300kNXh / UH-F300kNX / UH-600kNX / UH-600kNXh / UH-1000kNX / UH-1000kNXh / UH-F1000kNX / UH-F1000kNXh / UH-2000kNX / UH-2000kNXh / UH-F2000kNX / UH-F2000kNXh / UH-3000kNX / UH-F3000kNX / UH-4000kNX / UH-F4000kNX

InspeXio SMX-225CT FPD HR Plus Microfocus X-Ray Computed Tomography System
Shimadzu
SKU: inspeXio SMX-225CT FPD HR Plus

XSeeker 8000 Microfocus X-Ray Computed Tomography System
Shimadzu
SKU: Xseeker 8000

LCMS-8045RX Triple Quadrupole LC/MS/MS Mass Spectrometer
Shimadzu
SKU: LCMS-8045RX

Nexera Preparative Supercritical Fluid Chromatography System
Shimadzu
SKU: Nexera Prep SFC